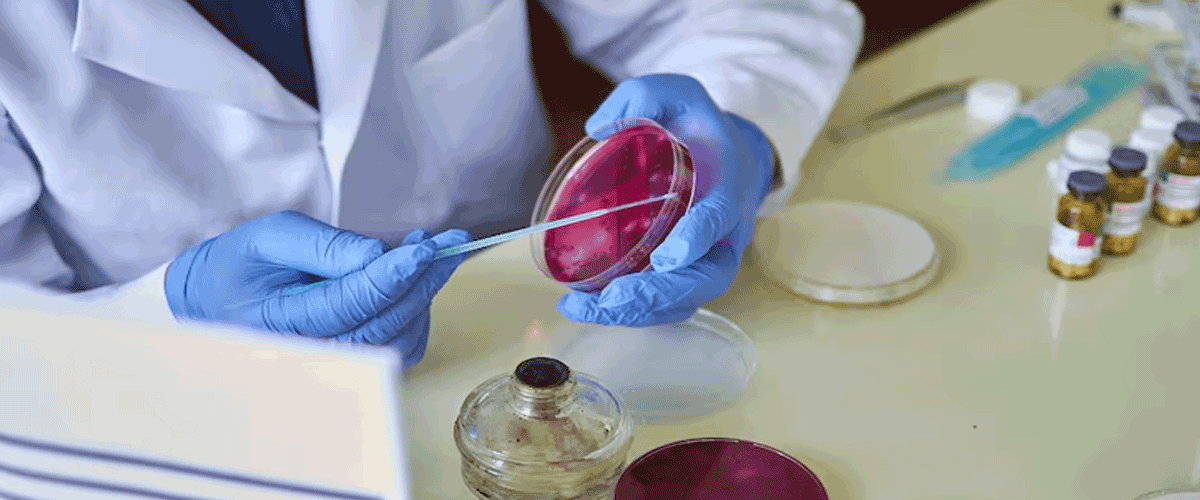
Nanobiotix and J&J’s JNJ-1900 Shows 69% Response Rate in Phase I Oesophageal Cancer Trial

(An Autonomous Body Recognized by Ministry of Commerce & Industry, Government of India)
Competency based placement focussed Education | Training | Research | Consultancy
Nanobiotix and J&J’s JNJ-1900 Shows 69% Response Rate in Phase I Oesophageal Cancer Trial
Nanobiotix and Johnson & Johnson’s radiotherapy-activated drug, JNJ-1900, has demonstrated promising results in a Phase I trial for oesophageal cancer. The nanoparticle-based injectable, tested with either proton or photon chemoradiotherapy (CRT), showed a disease control rate (DCR) of 85% and an objective response rate (ORR) of 69%, including six complete responses and three partial responses. The combination with photon CRT was feasible and well tolerated, with six patients experiencing treatment-related adverse events, two of which were Grade 3 or higher. Following the announcement, Nanobiotix shares rose 10%.
The ongoing trial is entering dose escalation and expansion phases, with interim results from the pivotal NANORAY-312 study in head and neck cancer expected in H1 2026. JNJ-1900 is also being studied in NSCLC, pancreatic cancer, and recurrent HNSCC, potentially offering a radiation-sensitising, immune-boosting therapy for patients with limited options, including those resistant to Keytruda or Opdivo.
06-10-2025
📰 Recent News
- Viridian Stock Drops Despite Positive Phase III Results in Thyroid Eye Disease
- Boston Scientific Reports Strong Trial Results for Heart and Clot Treatment Devices
- AstraZeneca’s Efzimfotase Alfa Shows Promise in Rare Bone Disorder Trials
- Idorsia Reports Positive Phase II Results for Paediatric Insomnia Drug
- J&J Reports Strong One-Year Results for Icotyde in Plaque Psoriasis
- BioMarin Halts Voxzogo Trials After Safety Concerns
- Imcivree Misses Primary Endpoints in Rare Obesity Trial
- Pfizer’s Atirmociclib Shows Promise in Breast Cancer Trial
- Lilly’s Retatrutide Shows Strong Results in Diabetes Trial
- Roche Halts Emugrobart Development for Muscle Disorders
